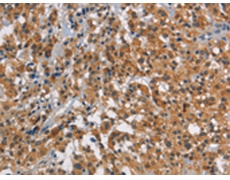
一抗

中文名稱: 兔抗SMAD9多克隆抗體
Background:
The protein encoded by this gene is a member of the SMAD family, which transduces signals from TGF-beta family members. The encoded protein is activated by bone morphogenetic proteins and interacts with SMAD4. Two transcript variants encoding different isoforms have been found for this gene.
Applications:
ELISA, WB, IHC
Name of antibody:
SMAD9
Immunogen:
Synthetic peptide of human SMAD9
Full name:
SMAD family member 9
Synonyms:
PPH2; MADH6; MADH9; SMAD8; SMAD8A; SMAD8B
SwissProt:
O15198
ELISA Recommended dilution:
1000-2000
IHC positive control:
Human thyroid cancer and Human gastric cancer
IHC Recommend dilution:
25-100
WB Predicted band size:
52 kDa
WB Positive control:
Mouse heart tissue
WB Recommended dilution:
200-1000


 購物車
購物車 幫助
幫助
 021-54845833/15800441009
021-54845833/15800441009